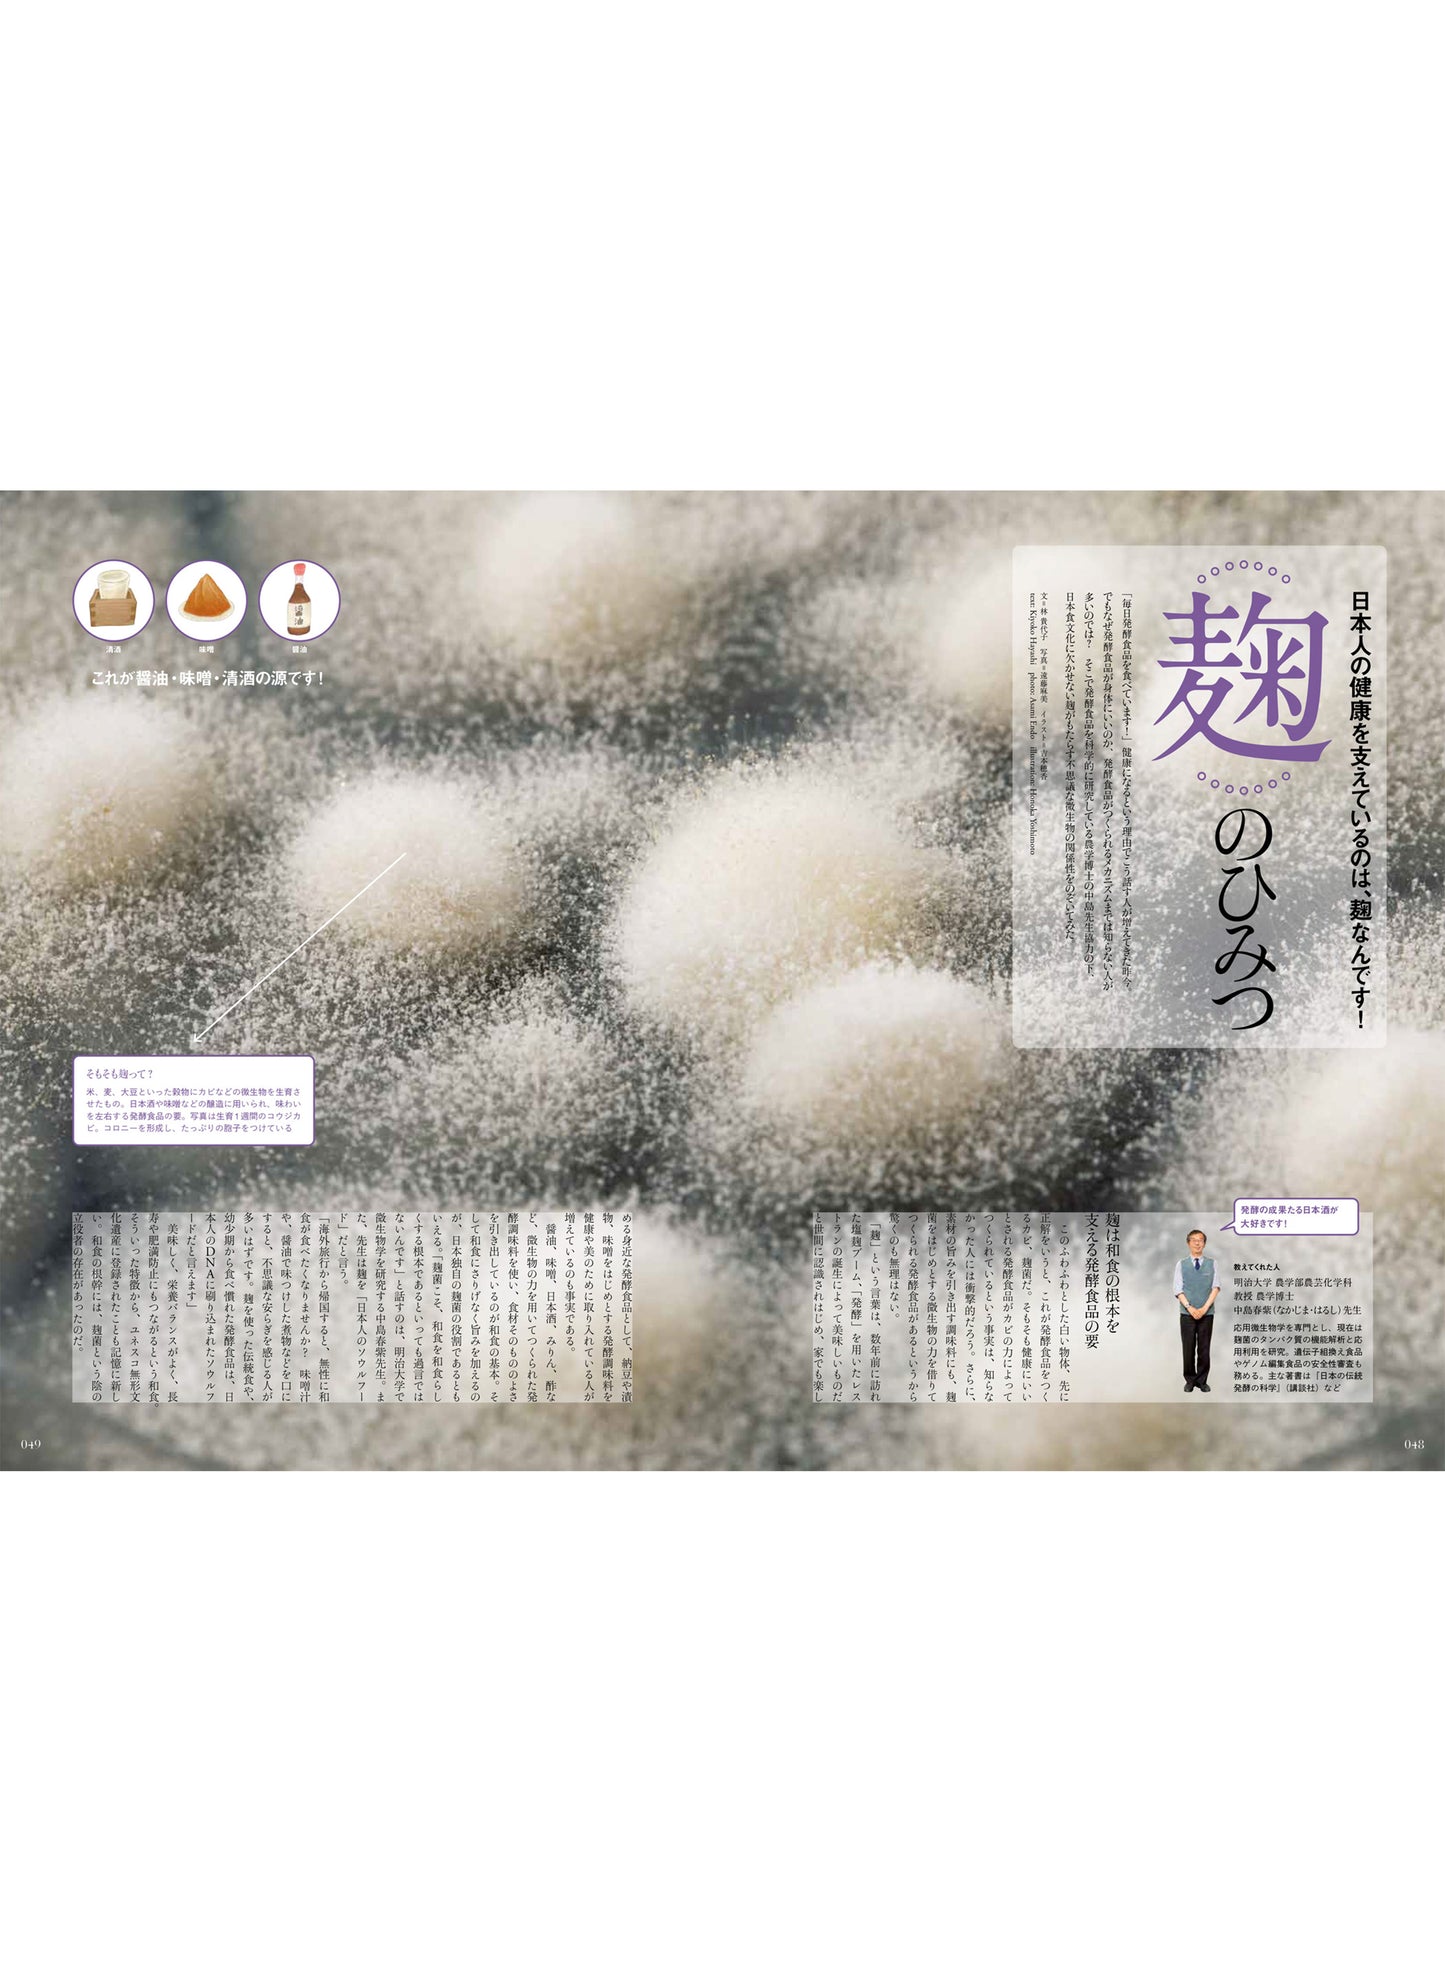

1
/
の
6
Discover Japan 2021年7月号「ととのう発酵。」2021/6/5発売
Discover Japan 2021年7月号「ととのう発酵。」2021/6/5発売
通常価格
¥1,100
通常価格
セール価格
¥1,100
単価
/
あたり
税込。
配送料はチェックアウト時に計算されます。
受取状況を読み込めませんでした
特集:
ととのう発酵。
世界中が健康の重要性を痛感している今、健康改善の一助として、「発酵」が注目されています。本特集は、そんな発酵食によって内面から"ととのう"一冊。発酵カルチャーを知り尽くす発酵デザイナー・小倉ヒラクさんを監修に迎えてお届けします!
納豆や甘酒、味噌汁、漬け物など、日本は世界と比べても発酵食の種類が圧倒的に多い“発酵大国”。発酵学者・小泉武夫先生に、そのルーツや健康的機能を語っていただきました。発酵食と新型コロナウイルスには重要な関係が?!
さらに、47都道府県独自の発酵食にもフィーチャー。「海」と「川」の発酵を軸に、地域の魅力を再発見できる「発酵ツーリズム」を提案します。
知っているようでまだまだ知らない“身近な発酵”で、身体も心もととのえて、この危機を一緒に乗り越えていきましょう!
日本全国送料無料
日本全国送料無料
- 直接ポストに投函・配達されます。
- 3冊以上のご購入は宅急便でお送りいたします。
- 国内限定配送です。
ご注文から3営業日以内発送
ご注文から3営業日以内発送
- ご注文確定から3営業日以内に発送いたします。
- 営業時間:11:00-21:00(土日祝を除く)
- 出版物に関しては14:00以降のご注文は翌営業日分として処理させていただきます。
- 予約商品に関しては商品入荷後3営業日以内に発送いたします。
- 翌日が土日祝の場合は次の営業日の発送となります。また、GW、お盆、年末年始期間は通常よりお時間を頂きますのでご了承下さい。
お届けの目安
お届けの目安
お問い合わせはこちら
お問い合わせはこちら
ご購入に関しては、特定商取引法に基づく表示内「ご購入に関して」をご参照ください。お問合せは、こちらのお問い合わせフォームからお願いいたします。
For International Customers
For International Customers
While we do not ship directly overseas, you can use our proxy shopping cart (WorldShipping BIZ). Please be aware that some items may not be eligible for proxy purchasing. For more details, please refer to the help section of the proxy cart.
共有